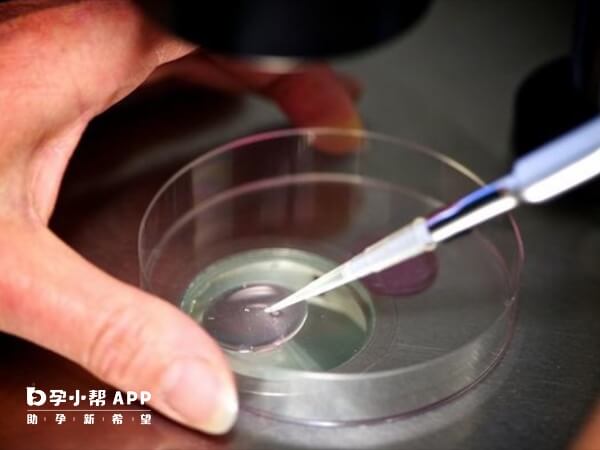
穴位埋线能够促进子宫内膜血液循环

做试管婴儿移植前进行穴位埋线具有多个方面的好处,能够促进子宫内膜血液循环,增加内膜厚度和容受性,从而为胚胎的着床和发育提供支持,同时还能参与内分泌与代谢调节,以此可缓解或改善焦虑的情绪,这样可为胚胎移植提供良好环境,进而提高试管婴儿移植的成功率。
试管婴儿移植前埋线是一种结合传统中医智慧与现代医学理念的辅助生殖技术,主要用于改善女性生殖内环境,提高胚胎着床成功率。如果大家想要了解试管婴儿移植前埋线的好处是什么,如下所示:
1、改善子宫内膜环境
试管婴儿移植前埋线,可通过穴位刺激调节内分泌,增强内膜血供和容受性,为胚胎着床创造更优条件,尤其对宫寒或内膜薄的患者效果更显著。
2、提高着床率
穴位埋线是中医针灸疗法的延伸,通过将可吸收蛋白线埋入特定穴位(如关元、子宫、三阴交等),持续刺激经络、调和气血,这样能够为胚胎提供良好的支持,从而提供胚胎的着床率。

3、缓解焦虑情绪
在试管婴儿移植前患者进行埋线,可以缓解过于焦虑的情绪,尤其是部分患者在移植前可能出现紧张情绪,那么埋线可辅助调节神经系统功能,减轻心理压力。
4、精准定位胚胎
试管婴儿移植前进行埋线,可固定胚胎位置,减少移植后移动风险,尤其适用于子宫形态异常者。
做试管婴儿移植前进行埋线,可以提高胚胎着床的成功率,但是并非每个患者都适合进行埋线,一般只有以下这几类人群才比较适合埋线,具体如下所示:
1、卵巢功能不佳者:如卵巢早衰、卵巢储备功能下降、卵巢低反应等,埋线可调节内分泌,改善卵巢功能,提高卵子质量和获卵数;
2、子宫内膜薄者:埋线能促进子宫内膜血液循环,增加内膜厚度和血流,为胚胎着床创造有利条件;
3、肥胖或代谢异常者:特别是多囊卵巢综合征患者,埋线可调节代谢、改善胰岛素抵抗,辅助减重,提高试管婴儿成功率;
4、备孕困难者:针对排卵障碍、自然受孕几率低等问题,埋线可作为辅助调理手段,提高整体生殖能力。